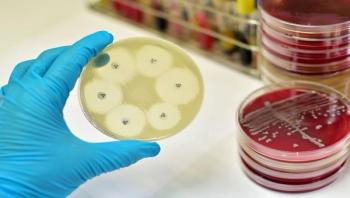

Environmental Services
Latest News












A fungal biopesticide that shows promise for the control of bed bugs is highly effective even against bed-bug populations that are insecticide resistant, according to research conducted by scientists at Penn State and North Carolina State universities. The study suggests that Aprehend, a mycoinsecticide developed at Penn State, likely will provide an important new tool for managing bed-bug infestations, which have surged in recent years.

More than 1 million healthcare associated infections (HAIs) occur within the U.S. healthcare system every year. According to a study per-formed by the Centers for Disease Control and Prevention (CDC), approximately 1 of every 25 hospitalized patients in the U.S. develop an HAI, meaning that nearly 650,000 patients contract one of these infections annually. These infections can lead to serious illness and result in the loss of thousands of lives each year. In addition they impose a tremendous financial burden, estimated to be more than a billion dollars annually in the U.S.











